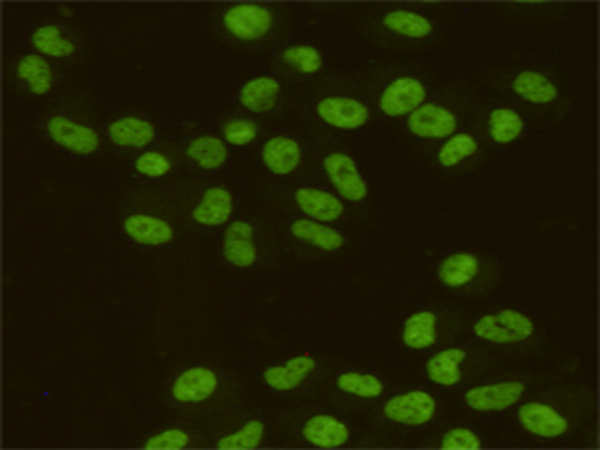
一抗

Background:
This gene encodes a DNA-binding protein which has high specificity for scaffold or matrix attachment region DNA elements (S/MAR DNA). This protein is thought to be involved in attaching the base of chromatin loops to the nuclear matrix but there is conflicting evidence as to whether this protein is a component of chromatin or a nuclear matrix protein. Scaffold attachment factors are a specific subset of nuclear matrix proteins (NMP) that specifically bind to S/MAR. The encoded protein is thought to serve as a molecular base to assemble a 'transcriptosome complex' in the vicinity of actively transcribed genes. It is involved in the regulation of heat shock protein 27 transcription, can act as an estrogen receptor co-repressor and is a candidate for breast tumorigenesis. This gene is arranged head-to-head with a similar gene whose product has the same functions. Multiple transcript variants encoding different isoforms have been found for this gene.
Applications:
WB, IF
Name of antibody:
SAFB
Immunogen:
Fusion protein of human SAFB
Full name:
scaffold attachment factor B
Synonyms:
HAP; HET; SAF-B; SAFB1; SAB-B1; SAF-B1
SwissProt:
Q15424
WB Predicted band size:
103 kDa
WB Positive control:
A431, MDA-MB-468, Breast cancer, ZR75-1, MCF7 and HelaNE cell lysates
WB Recommended dilution:
1000-5000
IF positive control:
Hela cells
IF Recommend dilution:
100-200
技術規格


 購物車
購物車 幫助
幫助
 021-54845833/15800441009
021-54845833/15800441009